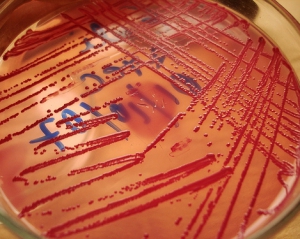

Жодного випадку зараження українців кишковою паличкою E.coli немає. Про це сьогодні сказав голова державної санітарно-епідеміологічної служби України Анатолій Пономаренко.
"Ситуація у нас керована і жодного випадку ні захворілих, ні підозрілих на захворювання цією страшною недугою у нас немає. Про це я офіційно заявляю і підтверджую", - додав він.
Пономаренко також зауважив, що Україна адекватно відреагувала на ситуацію з зараженням на кишкову паличку E.coli в Європі і наразі ситуація в Україні контрольована. Також, за його словами, Державна санітарно-епідеміологічна служба проводила консультації з керівництвом держави і спільно з ним прийшла до висновку, що заборона імпорту сільськогосподарської продукції тваринного та рослинного походження є передчасним і недоцільним кроком.
"Якщо б ми вийшли на те, що ризик, дійсно, є, ми одразу поставили до відома і загострили увагу керівництва держави, написали б на РНБО і Президенту, і прем'єр-міністру, і депутатам би повідомили, що нам потрібно своєчасно робити такі заходи", - додав він.
Нагадаємо, в результаті спалаху інфекції, викликаної мутованої кишковою паличкою E.coli, з початку травня в Європі померло, за різними даними, від 20 до 30 осіб. 10 червня в Німеччині повідомили, що джерелом зараження є пророщені насіння бобових. До цього були спростовані версії про те, що причиною епідемії могли стати огірки з Іспанії або паростки сої з Німеччини. Крім того, повідомлялось про постраждалих від цієї хвороби у Польщі та Словаччині.
Коментарі